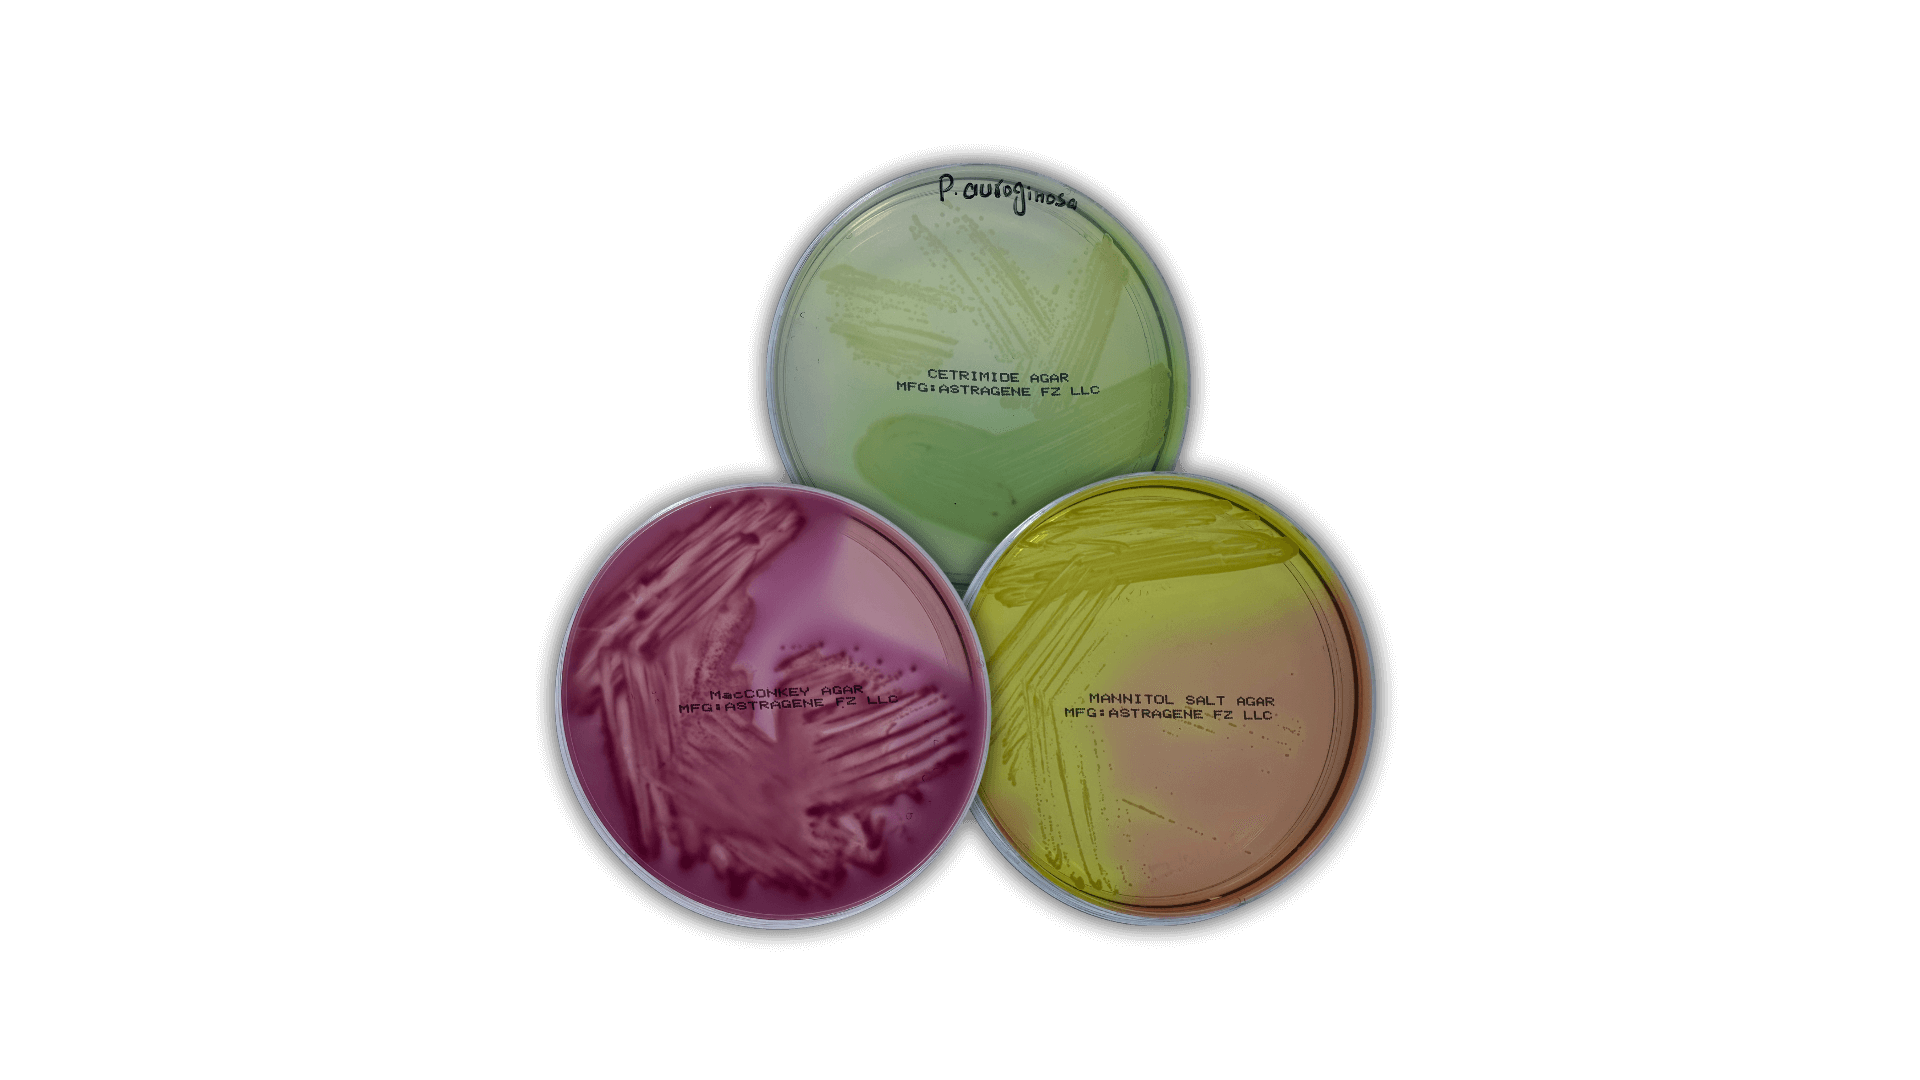
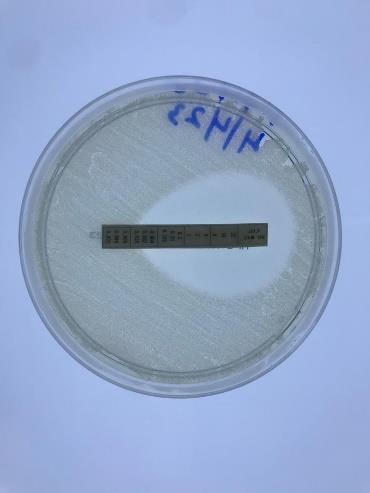

Our Story: Beyond the Lab
AstraGene is UAE’s first Molecular Diagnostics Manufacturing company located in Dubai at Dubai Science Park, UAE. Established in 2020, AstraGene LLC vision is to emerge as a leading manufacturer and marketer of in-vitro diagnostic reagents, kits and instruments both nationally and internationally. We make lab tests easy, with at home testing kits for a wide variety of tests. We have established collaborations across the globe for collaboration and contract manufacturing.
Popular Categories
Certifications and Accreditations
AstraGene is proud to hold prestigious certifications, including ISO 13485, ISO 17034, and Good Manufacturing Practices (GMP) from the UAE Ministry of Health. Additionally, our products are CE certified, reflecting our commitment to meeting international quality and safety standards.